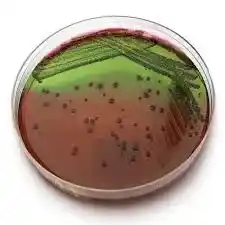

محیط کشت ائوزین متیلن بلو EMB کد109278 یکی از محیطهای کشت اختصاصی است که در آزمایشگاههای میکروبیولوژی برای تشخیص و شناسایی باکتریهای گرممنفی، خصوصاً انتروباکتریاسهها (Enterobacteriaceae)، استفاده میشود. این محیط با ترکیب مواد شیمیایی خاص و رنگهای ائوزین و متیلن بلو، امکان شناسایی سریع برخی باکتریها را فراهم میکند. در این مقاله، قصد داریم با جزئیات بیشتری به محیط کشت ائوزین متیلن بلو EMB کد109278 بپردازیم، تا شما بتوانید از این محیط کشت در شرایط مناسب استفاده کنید. محیط کشت ائوزین متیلن بلو EMB کد109278
محیط کشت ائوزین متیلن بلو EMB کد109278 فاقد املاح صفراوی می باشد. و بیشتر برای باکتری های گرم منفی روده ای مناسب می باشد. باکتری Ecoli در این محیط در حضور ائوزین متیلن بلو ایجاد جلای سبز فلزی می نماید ، که کلید تشخیص باکتری Ecoli نسبت به سایر باکتری های روده ای می باشد.
محیط کشت ائوزین متیلن بلو (EMB) یکی از ابزارهای کلیدی در تشخیص باکتریها است. این محیط قادر است با استفاده از ترکیب خاصی از مواد و رنگهای ائوزین و متیلن بلو، باکتریهای مختلف را بر اساس خصوصیات خود تمایز دهد.مشخصات محیط کشت ائوزین متیلن بلو EMB

محیط کشت ائوزین متیلن بلو EMB (Eosin Methylene Blue Agar) یکی از محیطهای کشت اصلی در آزمایشگاههای پزشکی است که برای شناسایی و جداسازی باکتریهای گرم منفی از جمله اشریشیا coli (E. coli) مورد استفاده قرار میگیرد. این محیط کشت شامل ترکیبی از موادی است که به باکتریها اجازه میدهد تا رشد کنند و به صورت جداگانه شناسایی شوند.
در محیط کشت ائوزین متیلن بلو EMB، باکتریهای گرم منفی که از نوع لاکتوز فرماندهنده هستند، به رنگ مشخصی در آمده و میتوان آنها را تشخیص داد. در این محیط کشت، باکتریهای لاکتوز فرماندهنده نیز قرمز میشوند و در نتیجه میتوان آنها را از باکتریهای لاکتوز نافرماندهنده که به رنگ آبی-سیاه درآیند، تمیز کرد.
استفاده از محیط کشت ائوزین متیلن بلو EMB برای شناسایی باکتریهای گرم منفی لاکتوز فرماندهده مانند E. coli جزء روشهای پایه در تشخیص ویروس کرونا (COVID-19) است. به عنوان مثال، در آزمایش پلیمراز زنجیره (PCR) که برای تشخیص ویروس کرونا استفاده میشود، نمونهها ابتدا در محیط کشت ائوزین متیلن بلو EMB کشت شده و سپس برای تشخیص ویروس کرونا از آنها استفاده میشود. محیط کشت ائوزین متیلن بلو EMB کد109278
بنابراین، محیط کشت ائوزین متیلن بلو EMB یکی از محیطهای کشت مهم در آزمایشگاههای پزشکی است که برای شناسایی باکتریهای گرم منفی لاکتوز فرماندهده مانند E. coli استفاده میشود. محیط کشت ائوزین متیلن بلو EMB کد109278
شرکت دانش پژوهان شیمی واردکننده اصلی مواد شیمیایی آزمایشگاهی بخصوص برند مرک آلمان و سیگماآلدریچ در ایران می باشد. جهت خرید محیط کشت می توانید با همکاران این مجموعه تماس حاصل نمائید.

محیط کشت ائوزین متیلن بلو ابتدا در دهههای ابتدایی قرن بیستم طراحی شد تا نیاز به شناسایی سریع باکتریهای رودهای را برآورده کند. این محیط به دلیل عملکرد بالا و دقت مناسب، به سرعت در بین میکروبیولوژیستها محبوب شد.
EMB در آزمایشگاههای تشخیص میکروبی برای شناسایی انواع مختلف باکتریها مانند اشریشیا کلی (E. coli) و سودوموناس استفاده میشود. محیط کشت ائوزین متیلن بلو EMB کد109278 محیط کشت ائوزین متیلن بلو EMB کد109278
این محیط شامل مواد مغذی، ائوزین Y و متیلن بلو است که باعث میشود انواع خاصی از باکتریها رنگ خاصی بگیرند و تشخیص آنها سادهتر شود. محیط کشت ائوزین متیلن بلو EMB کد109278 محیط کشت ائوزین متیلن بلو EMB کد109278
یکی از ویژگیهای مهم محیط کشت ائوزین متیلن بلو، خاصیت انتخابی آن برای باکتریهای گرممنفی است. این محیط باعث مهار رشد باکتریهای گرممثبت میشود. محیط کشت ائوزین متیلن بلو EMB کد109278

استفاده از EMB به تشخیص سریعتر و دقیقتر میکروبها کمک میکند و همچنین، امکان تجزیهوتحلیل راحتتر نمونههای آزمایشگاهی را فراهم میسازد. محیط کشت ائوزین متیلن بلو EMB کد109278 محیط کشت ائوزین متیلن بلو EMB کد109278
ابتدا نمونه را به دقت روی سطح محیط کشت EMB کد109278 انتقال داده و سپس آن را در دمای مناسب انکوباسیون قرار میدهند. محیط کشت ائوزین متیلن بلو EMB کد109278 محیط کشت ائوزین متیلن بلو EMB کد109278
تفسیر نتایج محیط کشت EMB
باکتریهایی مانند E. coli که لاکتوز را تخمیر میکنند، رنگ سبز متالیک میگیرند، در حالی که باکتریهای غیرفرمنتی مانند سودوموناس رنگ متفاوتی دارند. محیط کشت ائوزین متیلن بلو EMB کد109278 محیط کشت ائوزین متیلن بلو EMB کد109278
عوامل مؤثر بر دقت و صحت نتایج
عواملی نظیر دمای انکوباسیون و مقدار نمونه میتوانند بر دقت نتایج تأثیر بگذارند.

محیط کشت ائوزین متیلن بلو EMB (Eosin Methylene Blue Agar) علاوه بر شناسایی باکتری E. coli، قابلیت شناسایی سایر باکتریهای گرم منفی را نیز داراست. در این محیط کشت، باکتریهایی که قادر به فعالیت لاکتوز هستند و از نوع گرم منفی هستند، رشد میکنند. محیط کشت ائوزین متیلن بلو EMB کد109278
بعضی از باکتریهایی که میتوانند در محیط کشت ائوزین متیلن بلو شناسایی شوند، عبارتند از:
1- کلبسیلا: باکتریهایی که از نوع کلبسیلا هستند، در این محیط کشت به رنگ قرمز تیره نمایش داده میشوند.
2- اشریشیا های علاوه بر E. coli: باکتریهای دیگری از نوع اشریشیا مانند اشریشیا کلی، اشریشیا فئکالیس و اشریشیا های دیگر نیز در این محیط کشت رشد کرده و به صورت مشابه با E. coli به رنگ قرمز شفاف درآیند.
3- شیگلا: باکتریهایی که از نوع شیگلا هستند، در این محیط کشت به رنگ آبی تیره نمایش داده میشوند.
4- پروتئوس: باکتریهایی که از نوع پروتئوس هستند، در این محیط کشت به رنگ سبز تیره نمایش داده میشوند.
5- ارمنیایی: باکتریهایی که از نوع ارمنیایی هستند، در این محیط کشت به رنگ صورتی و تیره نمایش داده میشوند.
بنابراین، به علاوهی E. coli، محیط کشت ائوزین متیلن بلو EMB قابلیت شناسایی سایر باکتریهای گرم منفی را نیز داراست.
محیط کشت ائوزین متیلن بلو EMB (Eosin Methylene Blue Agar) به طور اصلی برای شناسایی و جداسازی باکتریهای گرم منفی به کار میرود و برای شناسایی باکتریهای گرم مثبت، مناسب نیست. این محیط کشت برای شناسایی باکتریهایی که قادر به فعالیت لاکتوز هستند و از نوع گرم منفی هستند طراحی شده است.
باکتریهای گرم مثبت مانند استافیلوکوکوس و استرپتوکوکوس، در محیط کشت ائوزین متیلن بلو به صورت سفید یا کرم روشن ظاهر میشوند و نمیتوان آنها را به صورت مشخصی از یکدیگر تمیز کرد. محیط کشت ائوزین متیلن بلو EMB کد109278
بنابراین، برای شناسایی باکتریهای گرم مثبت، محیط کشت دیگری مانند محیط کشت سابورود (Sabouraud agar) باید استفاده شود که برای رشد قارچها و باکتریهای گرم مثبت مناسب است. بنابراین، محیط کشت ائوزین متیلن بلو EMB نمیتواند به عنوان یک محیط کشت کلی برای شناسایی باکتریهای گرم منفی و مثبت استفاده شود و باید با توجه به نوع باکتری مورد نظر، محیط کشت مناسب منتخب شود. محیط کشت ائوزین متیلن بلو EMB کد109278
محیط کشت ائوزین متیلن بلو EMB (Eosin Methylene Blue Agar) برای شناسایی و جداسازی باکتریهای گرم منفی به طور گسترده استفاده میشود، اما باید توجه داشت که این محیط کشت ممکن است برای همهی باکتریهای گرم منفی مناسب نباشد. محیط کشت ائوزین متیلن بلو EMB کد109278
بعضی از باکتریهای گرم منفی ممکن است در محیط کشت ائوزین متیلن بلو رشد نکنند و یا به رنگهای مختلفی نسبت به E. coli واکنش نشان ندهند. برای مثال، باکتریهایی که به اکسیژن نیاز دارند و برای رشد آنها باید محیط کشتی با فضای هوای خالص استفاده شود، در محیط کشت ائوزین متیلن بلو رشد نخواهند کرد. محیط کشت ائوزین متیلن بلو EMB کد109278
به علاوه، بعضی از باکتریهای گرم منفی ممکن است به لاکتوز واکنش نشان ندهند و در نتیجه در این محیط کشت به رنگ آبی-سیاه نمایش داده شوند که ممکن است باعث اشتباه در تشخیص آنها شود.
بنابراین، برای شناسایی باکتریهای گرم منفی، باید با توجه به نوع باکتری مورد نظر، محیط کشت مناسب منتخب شود. در تشخیص و شناسایی باکتریها، انتخاب محیط کشت مناسب بسیار مهم است و باید با توجه به نوع باکتری، پرورش یافتن و شناسایی آنها را انجام داد. محیط کشت ائوزین متیلن بلو EMB کد109278

بله، برای شناسایی باکتریهای گرم منفی، محیط کشتهایی غیر از محیط کشت ائوزین متیلن بلو EMB نیز وجود دارد. در زیر به برخی از این محیط کشتها اشاره میکنیم: محیط کشت ائوزین متیلن بلو EMB کد109278
1. محیط کشت مقاومت به اسید: این محیط کشت برای شناسایی باکتریهای گرم منفی از نوع اسیدوفیل، مانند باکتریهای خانوادهی Enterobacteriaceae، استفاده میشود. محیط کشت ائوزین متیلن بلو EMB کد109278
2. محیط کشت مانمیلر: این محیط کشت علاوه بر جداسازی باکتریهای گرم منفی، برای جداسازی و رشد باکتریهای گرم مثبت نیز مناسب است. محیط کشت ائوزین متیلن بلو EMB کد109278
3. محیط کشت نوتریت: این محیط کشت برای شناسایی باکتریهای گرم منفی از نوع پروتئوس و کلبسیلا، استفاده میشود.
4. محیط کشت دیکلوکس: این محیط کشت برای شناسایی باکتریهای گرم منفی از نوع شیگلا، استفاده میشود.
5. محیط کشت هیمولیتیک: این محیط کشت برای شناسایی باکتریهای گرم منفی از نوع هموفیلوس، استفاده میشود.
به علاوه، برای جداسازی و شناسایی باکتریهای گرم منفی باید از تستهای بیوشیمیایی مختلف نیز استفاده کرد. به همین دلیل، انتخاب محیط کشت مناسب و تستهای بیوشیمیایی صحیح بسیار مهم است تا باکتریها به درستی شناسایی شوند.
بله، برای شناسایی باکتریهای گرم منفی، تستهای بیوشیمیایی مختلفی وجود دارد که برای تشخیص و جداسازی آنها استفاده میشود. برخی از این تستهای بیوشیمیایی عبارتند از: محیط کشت ائوزین متیلن بلو EMB کد109278
1. تست کاتالاز: این تست برای تشخیص وجود آنزیم کاتالاز در باکتریها استفاده میشود. باکتریهای گرم منفی مانند خانواده Enterobacteriaceae معمولاً دارای آنزیم کاتالاز هستند. محیط کشت ائوزین متیلن بلو EMB کد109278
2. تست اکسیداز: در این تست، با استفاده از نوارهای اکسیداز، وجود آنزیم اکسیداز در باکتریها تشخیص داده میشود. باکتریهایی که دارای آنزیم اکسیداز هستند، معمولاً از نوع گرم منفی هستند. محیط کشت ائوزین متیلن بلو EMB کد109278
3. تست یورهاز: در این تست، با استفاده از یک محیط کشت حاوی اوره، تشخیص داده میشود که آیا باکتری قادر به تجزیه اوره به آمونیاک و اسید کربوکسیلیک است یا خیر. باکتریهای گرم منفی مانند خانواده Enterobacteriaceae عموماً قادر به تجزیه اوره به آمونیاک هستند. محیط کشت ائوزین متیلن بلو EMB کد109278
4. تست شکلات: در این تست، با استفاده از یک محیط کشت حاوی هموگلوتینه، تشخیص داده میشود که آیا باکتری قادر به تجزیه هموگلوبین به هماتین و آهن است یا خیر. باکتریهای گرم منفی مانند Pseudomonas aeruginosa معمولاً قادر به تجزیه هموگلوبین هستند. محیط کشت ائوزین متیلن بلو EMB کد109278
همچنین، برای شناسایی و جداسازی باکتریهای گرم منفی، از تستهای دیگری مانند تست هایدروژن سولفید، تست اسیدی و قلیایی، و تست انتخابی نوتریت نیز استفاده میشود. محیط کشت ائوزین متیلن بلو EMB کد109278
محیط کشت ائوزین متیلن بلو EMB (Eosin Methylene Blue Agar) یکی از محیطهای کشت مورد استفاده در آزمایشگاههای میکروبیولوژی برای جداسازی و شناسایی باکتریهای گرم منفی است. این محیط کشت دارای خصوصیات فیزیکی و شیمیایی خاصی است که باعث میشود باکتریهای گرم منفی به خوبی در آن رشد کنند و به رنگهای مختلفی نسبت به E. coli واکنش نشان دهند. محیط کشت ائوزین متیلن بلو EMB کد109278
باکتریهایی که در محیط کشت ائوزین متیلن بلو رشد میکنند، به رنگ آبی-سیاه نمایش داده میشوند. این محیط کشت از رنگهای ائوزین و متیلن بلو تشکیل شده است که باعث تشکیل رنگهای خاص در حضور باکتریهای مختلف میشوند. باکتریهایی که به لاکتوز واکنش نشان میدهند، در این محیط کشت به رنگ قرمز تیره نمایش داده میشوند، در حالی که باکتریهایی که به لاکتوز واکنش نشان نمیدهند، به رنگ آبی-سیاه نمایش داده میشوند.
باکتریهایی که در محیط کشت ائوزین متیلن بلو رشد میکنند، معمولاً از خانواده Enterobacteriaceae هستند که در بین آنها باکتری E. coli نیز قرار دارد. با استفاده از این محیط کشت، میتوان باکتریهای مختلف گرم منفی را جدا کرده و شناسایی کرد. به علاوه، این محیط کشت برای شناسایی باکتریهایی که به لاکتوز واکنش نشان میدهند، بسیار مناسب است.
این محیط کشت به دلیل داشتن پارافین ، باعث رشد باکتری های بی هوازی می گردد. این محیط کشت محیطی مغذی و غنی برای باکتری های بی هوازی مانند کلستریدیوم است. این محیط معرف خاصی نداشته و هدف ایجاد محیط کشت مناسب برای باکتری های بی هوازی است. بعد از رشد باکتری برای تفریق باید بر روی محیط های افتراقی با شرایط بی هوازی جهت تشخیص باکتری مورد نظر پرداخت. محیط کشت ائوزین متیلن بلو EMB کد109278
محیط کشت ائوزین متیلن بلو EMB کد109278 به دلیل ویژگیهای منحصربهفرد خود، در تشخیص انواع باکتریهای گرممنفی بهویژه در تشخیص باکتری E. coli اهمیت زیادی دارد. با استفاده صحیح از این محیط و رعایت نکات لازم، میتوان به نتایج دقیقتری دست یافت. محیط کشت ائوزین متیلن بلو EMB کد109278 محیط کشت ائوزین متیلن بلو EMB کد109278
محیط کشت EMB چه نوع باکتریهایی را شناسایی میکند؟ محیط کشت ائوزین متیلن بلو EMB کد109278
این محیط بیشتر برای شناسایی باکتریهای گرممنفی نظیر اشریشیا کلی (E. coli) استفاده میشود.
چرا EMB برای باکتریهای گرممثبت مناسب نیست؟ محیط کشت ائوزین متیلن بلو EMB کد109278
ترکیبات موجود در EMB باعث مهار رشد باکتریهای گرممثبت میشود، بنابراین این محیط برای باکتریهای گرممنفی طراحی شده است. محیط کشت ائوزین متیلن بلو EMB کد109278 محیط کشت ائوزین متیلن بلو EMB کد109278
آیا استفاده از محیط کشت EMB برای افراد مبتدی مناسب است؟ محیط کشت ائوزین متیلن بلو EMB کد109278
استفاده از EMB نیازمند آشنایی با اصول اولیه کار در آزمایشگاه میکروبیولوژی است و بهتر است تحت نظر متخصصان استفاده شود. محیط کشت ائوزین متیلن بلو EMB کد109278 محیط کشت ائوزین متیلن بلو EMB کد109278
نتایج محیط کشت EMB چگونه تفسیر میشوند؟ محیط کشت ائوزین متیلن بلو EMB کد109278
باکتریهای لاکتوز تخمیرکننده رنگ سبز متالیک دارند، در حالی که دیگر باکتریها رنگهای متفاوتی به خود میگیرند.
چگونه میتوان EMB را به طور صحیح نگهداری کرد؟ محیط کشت ائوزین متیلن بلو EMB کد109278
EMB باید در مکانی خشک و خنک و به دور از نور مستقیم نگهداری شود تا خاصیت خود را حفظ کند.
شرکت دانش پژوهان شیمی یکی از بزرگترین وارد کنندگان و فروشندگان مواد شیمیایی و آزمایشگاهی بخصوص محصولات (مرک آلمان)محیط کشت ائوزین متیلن بلو EMB می باشد.که در زمینه واردات این محصولات از تجربه بسیار بالایی برخوردار است. شما می توانید جهت تهیه این محصولات (اصلی) با بخش فروش شرکت تماس گرفته و با کارشناسان این شرکت در ارتباط باشید و یا از طریق کانال واتساپ شرکت نام محصول به همراه میزان نیاز خود را ارسال تا در کمترین زمان پاسخ استعلام خود را دریافت نمائید. محیط کشت ائوزین متیلن بلو EMB کد109278 محیط کشت ائوزین متیلن بلو EMB کد109278
امیدواریم بتوانیم با ارائه محصولات اصلی و با بهترین کیفیت شما را برای رسیدن به اهدافتان یاری نمائیم.
جهت محصولات بیشتر واستعلام سریع قیمت محیط کشت ائوزین متیلن بلو EMB میتوانید از طریق کانال واتساپ شرکت با ارسال نام ماده و مقدار نیاز در کمترین زمان پاسخ استعلام خود را دریافت نمائید. محیط کشت ائوزین متیلن بلو EMB کد109278 محیط کشت ائوزین متیلن بلو EMB کد109278 محیط کشت ائوزین متیلن بلو EMB کد109278
راههای ارتباطی
شماره های تماس:
021-66859216
021-66859220 (ساعات تماس:8.30 الی 19)
واتساپ:09129618292 (24ساعت)
Last Updated on 10/25/2024 by adminm